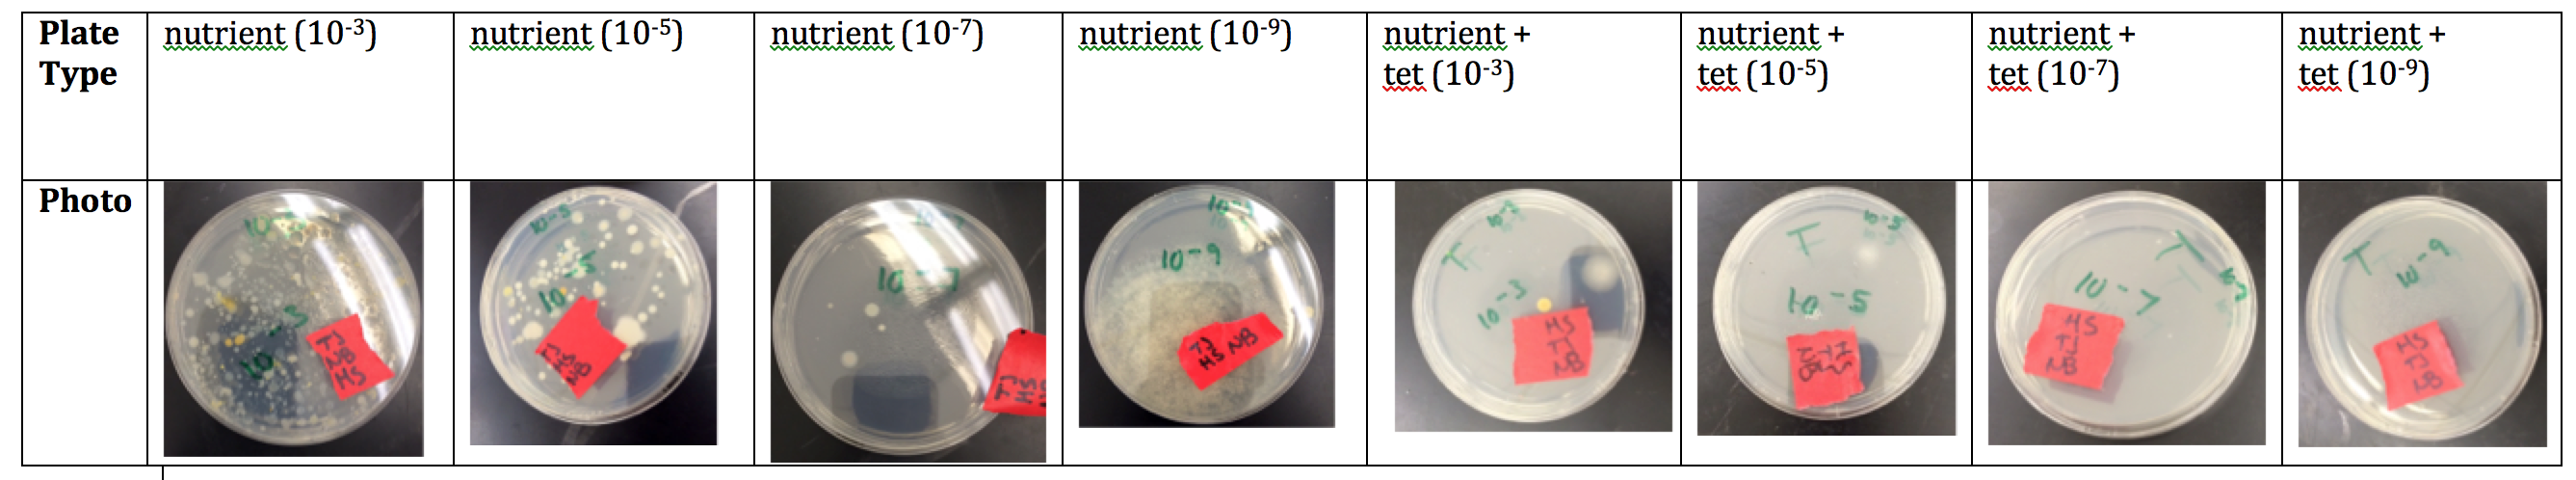

User:Hilary H. Strong
7/21/14
Lab 6: Bacteria Update
Introduction
Due to the evolution and prevalence of drug resistant bacteria, properly identifying bacteria before treatment rather than simply prescribing a broad-spectrum drug is becoming increasingly important. A gram stain represents one good method for classifying bacteria. Gram-negative bacteria with thinner layers of peptidoglycan in addition to a phospholipid bilayer are more difficult to eradicate than gram-positive bacteria. Furthermore, bacteria represent substantial morphological diversity (Freeman et al., 2014).
Materials/Methods
Procedure Using DNA from the spring semester’s class with the National Center for Biotechnology’s BLAST database to identify species of bacteria present in Transect #5.
Results
Discussion
Although our bacteria samples failed to be analyzed, by investigating those found Transect #5 in Spring 2014 we are able to gain a more detailed idea of the types of bacteria that inhabit the wildlife habitat. Bacteria play a vital role in shaping the ecosystem of Transect #5. For example they are primary producers, providing food for many organisms higher up in the food chain (Freeman et al. 2014).
Two of the bacteria identified from the DNA sequencing completed by groups in the Spring Semesters, using the BLAST database are Leclercia adecarboxylata and Chryseobacterium viscerum. L. adecarboxylata, a member of the Enterobacteriaceae family, is a rod-shaped, gram-negative bacterium that can cause infections of respiratory tract and blood (Bode Science Center). C. viscerum is also a rod-shaped, gram-negative bacterium (Zamora et al., 2012).
Possible sources of error in identifying bacteria include contamination, either between samples or from researchers.
References
Bentley, Meg, Kathryn Walters-Conte, and Nancy Zeller. Bio210. N.p.: n.p., 2014. Print.
Bode Science Center. "Leclercia Adecarboxylata (bacteria)." Leclercia Adecarboxylata. Paul Hartmann AG, n.d. Web. 28 July 2014. <http://www.bode-science-center.com/center/relevant-pathogens-from-a-z/leclercia-adecarboxylata.html>.
Freeman, Scott, Kim Quillin, Emily Taylor, Jon Monroe, Lizabeth Allison, and Greg Podgorski. Biological Science. 5th ed. Glenview: Pearson, 2014. Print.
National Center for Biotechonology Information. "Standard Nucleotide BLAST." BLAST: Basic Local Alignment Search Tool. National Library of Medicine, n.d. Web. 26 July 2014.
Zamora, L., A. I. Vela, M. A. Palacios, C. Sanchez-Porro, L. A. Svensson-Stadler, L. Dominguez, E. R. B. Moore, A. Ventosa, and J. F. Fernandez-Garayzabal. "Chryseobacterium Viscerum Sp. Nov., Isolated from Diseased Fish." International Journal Of Systematic And Evolutionary Microbiology 62.Pt 12 (2012): 2934-940. PubMed. Web. 28 July 2014.
HHS
7/14/14
Lab 5: Invertebrates
Introduction
There are 14 phyla of invertebrates, ranging from the simple Porifera, whose cells lack the ability to form formal tissues, to more complicated Cnidaira and Ctenophora who contain two types of germ tissue, ectoderm and endoderm, to complex animals with an additional third type of germ tissue, mesoderm (Bentley et al. 2014). As invertebrates increase in complexity they move from radial to bilateral symmetry and through specialization begin to develop basic circulatory and nervous systems (Bentley et al. 2014).
Materials/Methods
Procedure I: Acelomates, Pseudocoelomates, and Coelomates
1. Observe cross section slides of Planaria, nemotaode, and Annelida, with compound microscope and compare structure and muscular systems
2. Observe living anematodes and look at movement (Bentley et al. 2014)
Procedure II: Analyzing the invertebrates from Berlese Funnel setup
1. Take apart the Berlese funnel
2. Carefully pour the top half of the preservative and organisms into one petri dish and the bottom half into a second
3. Tease out visible organisms from debris and transfer to depression slides
4. Observe slides using compound microscope
5. Identify the class and order of five organisms found
6. Measure the organisms and record observations (Bentley et al. 2014)
Procedure III: Vertebrates in transect #5
1. Contemplate vertebrates that might live in your transect (Bentley et al. 2014)
Results
Proposed food web for identified organisms found in transect #5.
Discussion
The worms increased in complexity from the simple planaria to the nematode to the most complex annelida (Bentley et al. 2014). The only life sample available for observation was the nematode, which exhibited an undulating movement similar to the sine function.
As the leaf litter samples placed in the Berlese funnel were taken from the ground, the majority of organisms are arthropods (Bentley et al. 2014). The organisms found in transect #5 range in size from .50 mm to 6.75 mm. Both the smallest and the largest organisms found in transect #5 were diptera, flies. Diptera were also the most common organism with two found in different parts of sample.
Odocileus virginianus, commonly known as white-tailed deer are very common in this region. O. virginianus would be attracted to transect #5 because of the variety of shrubs and bushes available for sustenance, and they particularly like parts of maple trees of which there is one in transect #5 (Dewey).
The diet of passer domesticus is heavily reliant on seeds. Thus, transect #5 with its many plants and trees would provide a delicious buffet for them to sample (passer domesticus).
Thamnophis sirtalis is would find transect #5 suitable because of its rocks and varied terrain. T. sirtalis have a varied diet, but commonly eat insects and thus the many plants of transect #5 would attract both (Zimmerman).
Transect #5 would be an ideal environment for turdus migratorius because it offers small trees and bushes for them to nest in as well as open space and grasses for them to forage for food in (Shapiro).
Homo sapiens would be attracted to transect #5 because of the shade which helps cool their bodies and retain vital water.
Ultimately the carrying capacity of transect #5 depends on the quantity of primary producers and decomposers who lie at the bottom of the food web. Their existence provides nutrients for organisms at higher trophic levels in the food web, e.g., the primary, secondary, and tertiary consumers. Together all the organisms identified in transect #5 represent a community (Freeman et al. 2014).
Difficulty with this lab arises from the fact that pace of lab has far outstripped that of lecture, which makes completing certain tasks like constructing the food web onerous. In the future, if the two were better matched then the lab portion would be considerably easier. At times the dichotomous key was a struggle to use and could benefit from the addition of example pictures of the features, as to a lay person some of distinguishing features were unheard of.
References
Bentley, M., Walters-Conte, K., & Zeller, N. (2014). Bio210.
Birds of D.C. - Encyclopedia of life. (n.d.). Retrieved July 16, 2014, from http://eol.org/collections/65
Dewey, T. and . 2003. "Odocoileus virginianus" (On-line), Animal Diversity Web. Accessed July 16, 2014 at http://animaldiversity.ummz.umich.edu/accounts/Odocoileus_virginianus/
Freeman, S., Quillin, K., Taylor, E., Monroe, J., Allison, L., & Podgorski, G. (2014). Biological science (5th ed.). Glenview, IL: Pearson.
House Sparrow (Passer domesticus) - Information on House Sparrow - Encyclopedia of Life. (n.d.). Retrieved July 16, 2014, from http://eol.org/pages/922241/overview
Shapiro, L. (n.d.). American Robin (Turdus migratorius) - Information on American Robin - Encyclopedia of Life. Retrieved July 16, 2014, from http://eol.org/pages/1177506/overview Ward's Natural Science. (1988). A simple major dichotmous key to 18 major orders of insects [Brochure]. Rochester, NY: Author.
Zimmerman, R., & Poor, A. (n.d.). Thamnophis sirtalis: Common garter snake. Retrieved July 16, 2014, from http%3A%2F%2Fanimaldiversity.ummz.umich.edu%2Faccounts%2FThamnophis_sirtalis%2F
HHS
7/10/14
Lab 4: Plantae and Fungi
Introduction
Modern land plants are believed to have evolved from green algae. The first terrestrial plants were similar to bryophytes, mosses that adapted to live on land because of competition for resources in water. In order to make the transition, bryophytes had to combat the large temperature range on land, due to the lower specific heat of land versus water, acquire water and nutrients necessary for survival, and reproduce (Bentley et al. 2014). The next phyla to emerge was tracheophytes as plants began to develop a vascular system. Eventually, angiosperms evolved with the ability to propagate widely using the wind to expand their physical range. Fungi play an important role as decomposers, which release carbon dioxide, nitrogen into the soil, and water. Depending on their type, they consume nonliving or living organic matter. They range from unicellular to highly specialized (Bentley et al. 2014).
By studying samples of bryophytes, pteriodophyta, and angiosperms from transect #5, one is able to compare the rise of differentiation in plants as vascular and reproductive systems increased in complexity. Furthermore, the variety of phyla in the transect illustrates the ability of plants to adapt to different niches within a small area in order to manipulate the available resources.
Materials/Methods
Procedure I: Collect five plant samples from transect
1. Take two Ziploc bags to transect
2. In the first bag, collect a litter leaf sample of soil, dead leaves, and plant matter for the Berlese funnel
3. Pick five plants and take representative samples from them and place in the second bag
Procedure II: Observe Plant Vascularization
1. Use compound microscope to observe samples of moss, Mnium, and lily stem
2. Observe the xylem and phloem layers of the lily stem
3. Observe the vascularization of the plant samples from the transect (Bentley et al. 2014)
Procedure III: Specialization of Plant Cells
1. Observe the moss and leaves of the angiosperm to identify specialized structures
2. Examine the transect samples to identify specialized structures (Bentley et al. 2014)
Procedure IV: Plant Reproduction
1. Observe the moss, Polytrichum, and identify the gametophytes and sporophyte
2. Compare to hetereosporous angiosperm
3. Dissect lily flower to identify reproductive structures: anther, pollen, stigma, style, ovules (within the ovary), embryo sac, etc.
4. Examine the seed to determine if it is a monocot or dicot
5. Dissect seeds from transect samples for comparison (Bentley et al. 2014)
Procedure V: Observe Fungi
1. Use dissecting microscope to observe Rizophus stolonifer, commonly known as black bread mold
2. Identify hypae filaments, collectively mycelium, and sporangia, which contains the spores
3. Flip over the sample and identify rhizoids, which act as the roots (Bentley et al. 2014)
Procedure VI: Set up Berlese Funnel for Invertebrate Collection
1. Add 25 mL of diluted ethanol to 50 mL tube
2. Add a screen to the bottom of the funnel, adjust, and tape sides of the screen to hold leaf litter in place
3. Add leaf litter to the funnel
4. Attach two rings to a ring stand to immobilize the funnel and tube
5. Wrap the funnel in parafilm to prevent evaporation of the preservative
6. Set up light source 1-2 inches above the above leaf litter, sitting in the funnel
7. Cover setup with foil
8. Leave until next lab (Bentley et al. 2014)
Results
Transect #5 on 7/10/14.
Plant samples taken from transect #5.
Sample 2 in Transect #5.
Discussion
Sample 1 is a dicot angiosperm. Unlike their earlier ancestors, angiosperms have a more specialized form of sexual reproduction which enables them to produce both the male and female gametophyte, the microspore and megaspore, respectively. The double fertilization of angiosperms allows them to produce both a seed and an endosperm that provides nutrients along with the cotyledon for the zygote as it develops into a plant (Bentley et al. 2014).
Sample 2 is a bryophyte, an early plant with minimal specialization. Instead of roots, it has rhizoids, which increase its available surface area and allow it absorb water and diffuse gases. Rhizoids also enable bryophytes to anchor to the ground (Bentley et al. 2014). Bryophytes appear in a few patches along the ground of transect #5.
Transect #5 is an oasis for a variety of different plantae from simple bryhophytes to complex angiosperms, their coexistence illustrates the ability of members of the plantae kingdom to adapt similarly and differently to similar environments. Additionally, it raises questions about the number of niches in a single transect and how broad classification of a niche should be. Perhaps further studies should be done on micro-transects within transect #5 to identify and differentiate among the factors affecting life there.
Without extensive knowledge of plants, it is very difficult to determine the genera of some of the samples. As the majority of the data is qualitative, the possibilities for error in identification were compounded by each observation made. Better note taking and increased use of technology paired with a dichotomous key would make this lab easier and more informative. Perhaps a guided botanical tour of the campus would also prove useful for making proper identifications.
References
Bentley, M., Walters-Conte, K., & Zeller, N. (2014). Bio210.
Christenhusz, M. (n.d.). Angiopteris evecta (giant fern or king fern). Retrieved July 14, 2014, from http://www.nhm.ac.uk/nature-online/species-of-the-day/biodiversity/loss-of-habitat/angiopteris-evecta//index.html
Freeman, S., Quillin, K., Taylor, E., Monroe, J., Allison, L., & Podgorski, G. (2014). Biological science (5th ed.). Glenview, IL: Pearson.
Harris, S. (n.d.). Liriope. Retrieved July 14, 2014, from http://www.sustainable-gardening.com/plants/perennials/liriope
Vanderbilt University. (n.d.). Bioimages. Retrieved July 14, 2014, from http://www.cas.vanderbilt.edu/bioimages/species/frame/coal2.htm
HHS
7/7/14
Lab 3: Microbiology and Identifying Bacteria with DNA Sequences
Introduction
Due to their small size, around 10 um, a microscope is necessary to study individual bacteria. In addition to comparing morphological differences notably, a stain can be applied to the sample to aid in identifying the bacterium. One defining characteristic of bacteria is the thickness of the layer of peptidoglycan,a component of the cell wall. The Gram stain is a good method for differentiating between thick peptidoglycan and thin ones, as thick layers hold onto the crystal violet dye used in the stain. Determining if the bacteria is gram-positive, has a thick layer of peptidoglycan, or gram-negative, has a thinner layer of peptidoglycan is useful picking the most effective antibiotic (Bentley et al. 2014).
Furthermore, a bacteria can be identified by performing a polymerase chain reactions (PCR) with specific primer sequences. Identifying species in this way is also useful for piecing together the phylogenetic relationships among species (Bentley et al. 2014).
Methods/Materials
Procedure I: Quantifying and Observing Microorganisms
1. Examine the eight agar plates from the Hay Infusion Culture, looking for colonies
2. Count and record the number and type of colonies on each plate (Bentley et al. 2014)
Procedure II: Antibiotic Resistance
1. Compare the colonies on the agar nutrient plates to those on the agar + tetracycline plates (Bentley et al. 2014)
Procedure III: Bacteria Cell Morphology Observations
1. Add a sample from three chosen colonies to three sterile tubes filled with 100 uL of water
2. Incubate the samples for 10 minutes at 100 °C
3. Add the samples to the centrifuge for 5 minutes at 13,400 rpm
4.Prepare 3 PCR tubes by labeling them and adding 20 uL of primer and mix
5. Add 5 uL of the supernatant from the centrifuge sample to the PCR tubes
6. Move the tubes to the PCR machine (Bentley et al. 2014)
Procedure IV: Set up PCR for 16s Sequencing
1. Add a sample from three chosen colonies to three sterile tubes filled with 100 uL of water
2. Incubate the samples for 10 minutes at 100 °C
3. Add the samples to the centrifuge for 5 minutes at 13,400 rpm
4.Prepare 3 PCR tubes by labeling them and adding 20 uL of primer and mix
5. Add 5 uL of the supernatant from the centrifuge sample to the PCR tubes
6. Move the tubes to the PCR machine (Bentley et al. 2014)
Data and Observations
Agar and Agar + Tetracycline Plates
Results of the colony count.
Drawings of Bacteria Cells
Discussion/Conclusion
The appearance and smell of the Hay Infusion Culture might change from week to week because as the environment in the culture changes due to fluctuations in factors like temperature and light exposure, new organisms may grow while existing populations could die out or mutate in order to adapt.
There are significantly more colonies and varieties of bacteria as well on the agar nutrient plates than the agar plus tetracycline plates. This indicates that the bacteria is susceptible to tetracycline and thus the tetracycline inhibited bacteria from growing on the plates with it. Three species of bacteria grew on the tetracycline plates and thus were unaffected, or resistant to the antibiotic.
Tetracycline targets gram positive and gram-negative bacteria among many other microorganism. Tetracycline blocks aminoacyl-tRNA from to the acceptor site on the ribosome, thus preventing protein synthesis (Chopra & Roberts, 2001).
References
Bentley, M., Zeller, N., & Walters-Conte, K. (2014). Bio210.
Bonan, N. (2014, July 7). Agar 10-9 wet mount [Drawing].
Chopra, I., & Roberts, M. (2001). Tetracycline Antibiotics: Mode of Action, Applications, Molecular Biology, and Epidemiology of Bacterial Resistance. Microbiology and Molecular Biology Reviews, 65(2), 232-260. doi: 10.1128/MMBR.65.2.232-260.2001
Freeman, S., Quillin, K., Taylor, E., Monroe, J., Allison, L., & Podgorski, G. (2014). Biological science (5th ed.). Glenview, IL: Pearson.
Rutgers University. (n.d.). Colony morphology: Describing bacterial colonies [Brochure]. Author. Retrieved July 9, 2014, from http://www.rci.rutgers.edu/~microlab/CLASSINFO/
HHS
7/2/14
Lab 2: Identifying Algae and Protists
Introduction
If populations of organisms evolve as they adapt to the stresses of their environment by natural selection, then one would expect organisms to vary if the environment varies. In the Hay Infusion Culture, one would expect more photosynthetic organisms, like algae, near the top because of access to light and more protists towards the bottom.
If the bacteria are not resistant to antibiotics then there would be greater populations of bacteria in the agar than the tetracycline plates. If the bacteria are resistant to tetracycline, then they will thrive in the tetracycline plates, especially if other species they would normally compete for nutrients with are not resistant and are wiped out.
Materials/Methods
Procedure I: How to Use a Dichotomous Key
1. Prepare wet mount of known organism
2. Use dichotomous key to confirm identify of the organism
3. Record observations of organism using compound microscope with 4x, 10x, and 40x objective lenses
Procedure II: Observing Hay Infusion Culture
1. Collect Hay Infusion Culture and make initial observations 2. Prepare two wet mounts from the top and bottom of the culture respectively 3. Observe the four samples under the compound microscope and use the dichotomous key to identify four organisms
Procedure III: Preparing and Plating Serial Dilutions 1. Ready materials by labeling four tubes with sterile broth with their final concentrations as well as two sets of four nutrient plates, one set of agar, and a second of agar plus tetracycline 2. Mix up the Hay Infusion Culture to ensure a representative sample 3. Add 100 uL to the first tube, mix well 4. Move 100 uL from the first tube to the second, mix well 5. Repeat twice more, until four tubes of decreasing concentration are prepared 6. Pipette 100 uL from each tube onto each pair of corresponding plates 7. Replace the covers of the plates and flip plates then upside down 8. Set aside the plates for incubation
Data and Observations
Hay Culture Infusion: smells like mildew; appears murky with layer of mud at the bottom, some floating dirt, the opacity and brown color both increase as the depth of the sample increases
Top-down View of Hay Infusion Culture
Straight-ahead View of Hay Infusion Culture
Diagram of Serial Dilution of Hay Infusion Culture
Conclusion
Paramecium is a protist which digests nutrients for energy, its cells are membrane bound with organelles to promote specialization, it has genes which encode hereditary information stored in its two nuclei, it is part of the alveolata lineage, and finally it can reproduce asexually or sexually, (Bentley et al. 2014) and (Freeman et al. 2014)
If the Hay Infusion Culture is left over time it is expected that the population of protists would waste away from lack of nutrients, while the algae would thrive, assuming they have access to light, because of their ability to photosynthesize. Additional organisms could appear as the environment continues to change.
References
Bentley, M., Zeller, N., & Walters-Conte, K. (2014). Bio210.
Freeman, S., Quillin, K., Taylor, E., Monroe, J., Allison, L., & Podgorski, G. (2014). Biological science (5th ed.). Glenview, IL: Pearson.
Ward's Natural Science Establishment, Inc. (2002). Ward's free-living protozoa [Brochure]. Rochester, NY: Author.
HHS
7/1/14
Lab 1: Biological Life at AU
Introduction
In order to better understand the diversity of ecological life continually evolving via natural selection, compare samples of three of the 9,000 or so, species that comprise the Volvocine line. Observe the similarities and differences resulting from evolution in the volvocine line, especially related to motility, sexual reproduction, organization, and specialization. Then, examine a transect of the AU campus for a macro introduction to ecology in our surroundings. Differentiate between the biotic and abiotic elements in the transect to understand the stresses placed on the populations which reside there.
Methods/Materials
Part I: The Volvocine Line 1. Prepare wet mounts of chlamydomonas and gonium 2. Observe using compound microscope 3. Prepare depression slide of volvox 4. Observe using compound microscope
Part II: Observing a Niche at AU
1. Analyze 20 by 20 meter transect
2. Observe general surroundings
3. Record notable abiotic and biotic components
4. Collect soil/surface plant sample in 50 mL conical tube
5. Prepare a Hay Infusion Culture by mixing 10-12 g of the sample, 500 mL of distilled water, 0.1 g dried milk, in plastic jar for 10 seconds
6. Remove top of Hay Infusion Culture and set aside
Data and Observations
Differences among species of the Volvocine Line.
Transect #: 5
Location-outside Hughe's Hall
(Odunlami 2014)
(Odunlami 2014)
Topography-slightly slanted
Abiotic Factors
Stone- rocks, pebbles Other- bench
Biotic Factors
Trees-ficus, other small trees Plants- day lily, modo grass, moss, daffodils, shrubs Animals- ants
Conclusion
This transect is diverse in biotic and abiotic components and thus contains organisms of different types.
References
Bentley, M., Zeller, N., & Walters-Conte, K. (2014). Bio210.
Environmental Protection Agency. (2012, June 25). Natural resources: Plankton. Retrieved from http://www.epa.gov/glnpo/image/viz_nat6.html
Freeman, S., Quillin, K., Taylor, E., Monroe, J., Allison, L., & Podgorski, G. (2014). Biological science (5th ed.). Glenview, IL: Pearson.
Office of University Architect. (2013, August 1). American University - Main campus [Map].
Protist Infomration Server. (n.d.). Protist images: Chlamydomonas reinhardtii. Retrieved July 7, 2014, from http://protist.i.hosei.ac.jp/pdb/images/chlorophyta/chlamydomonas/Euchlamydomonas/reinhardtii/sp_09.html
Odunlami, T. (2014, June 30). [Photograph].
University of New Hampshire, & Baker, A. L. (2012). Phytoplankton key - Phycokey - Volvox images. Retrieved from http://cfb.unh.edu/phycokey/Choices/Chlorophyceae/colonies/colonies_flagellated/VOLVOX/Volvox_Image_page.html
HHS
Contact Info

- Hilary H. Strong
- American University
- Address 1
- Address 2
- City, State, Country etc.
- Email me through OpenWetWare
I work in the Your Lab at XYZ University. I learned about OpenWetWare from Bio 210, and I've joined because To participate in Biology 210..
Education
- 2013, B.A., Vanderbilt University
Research interests
- Interest 1
- Interest 2
- Interest 3